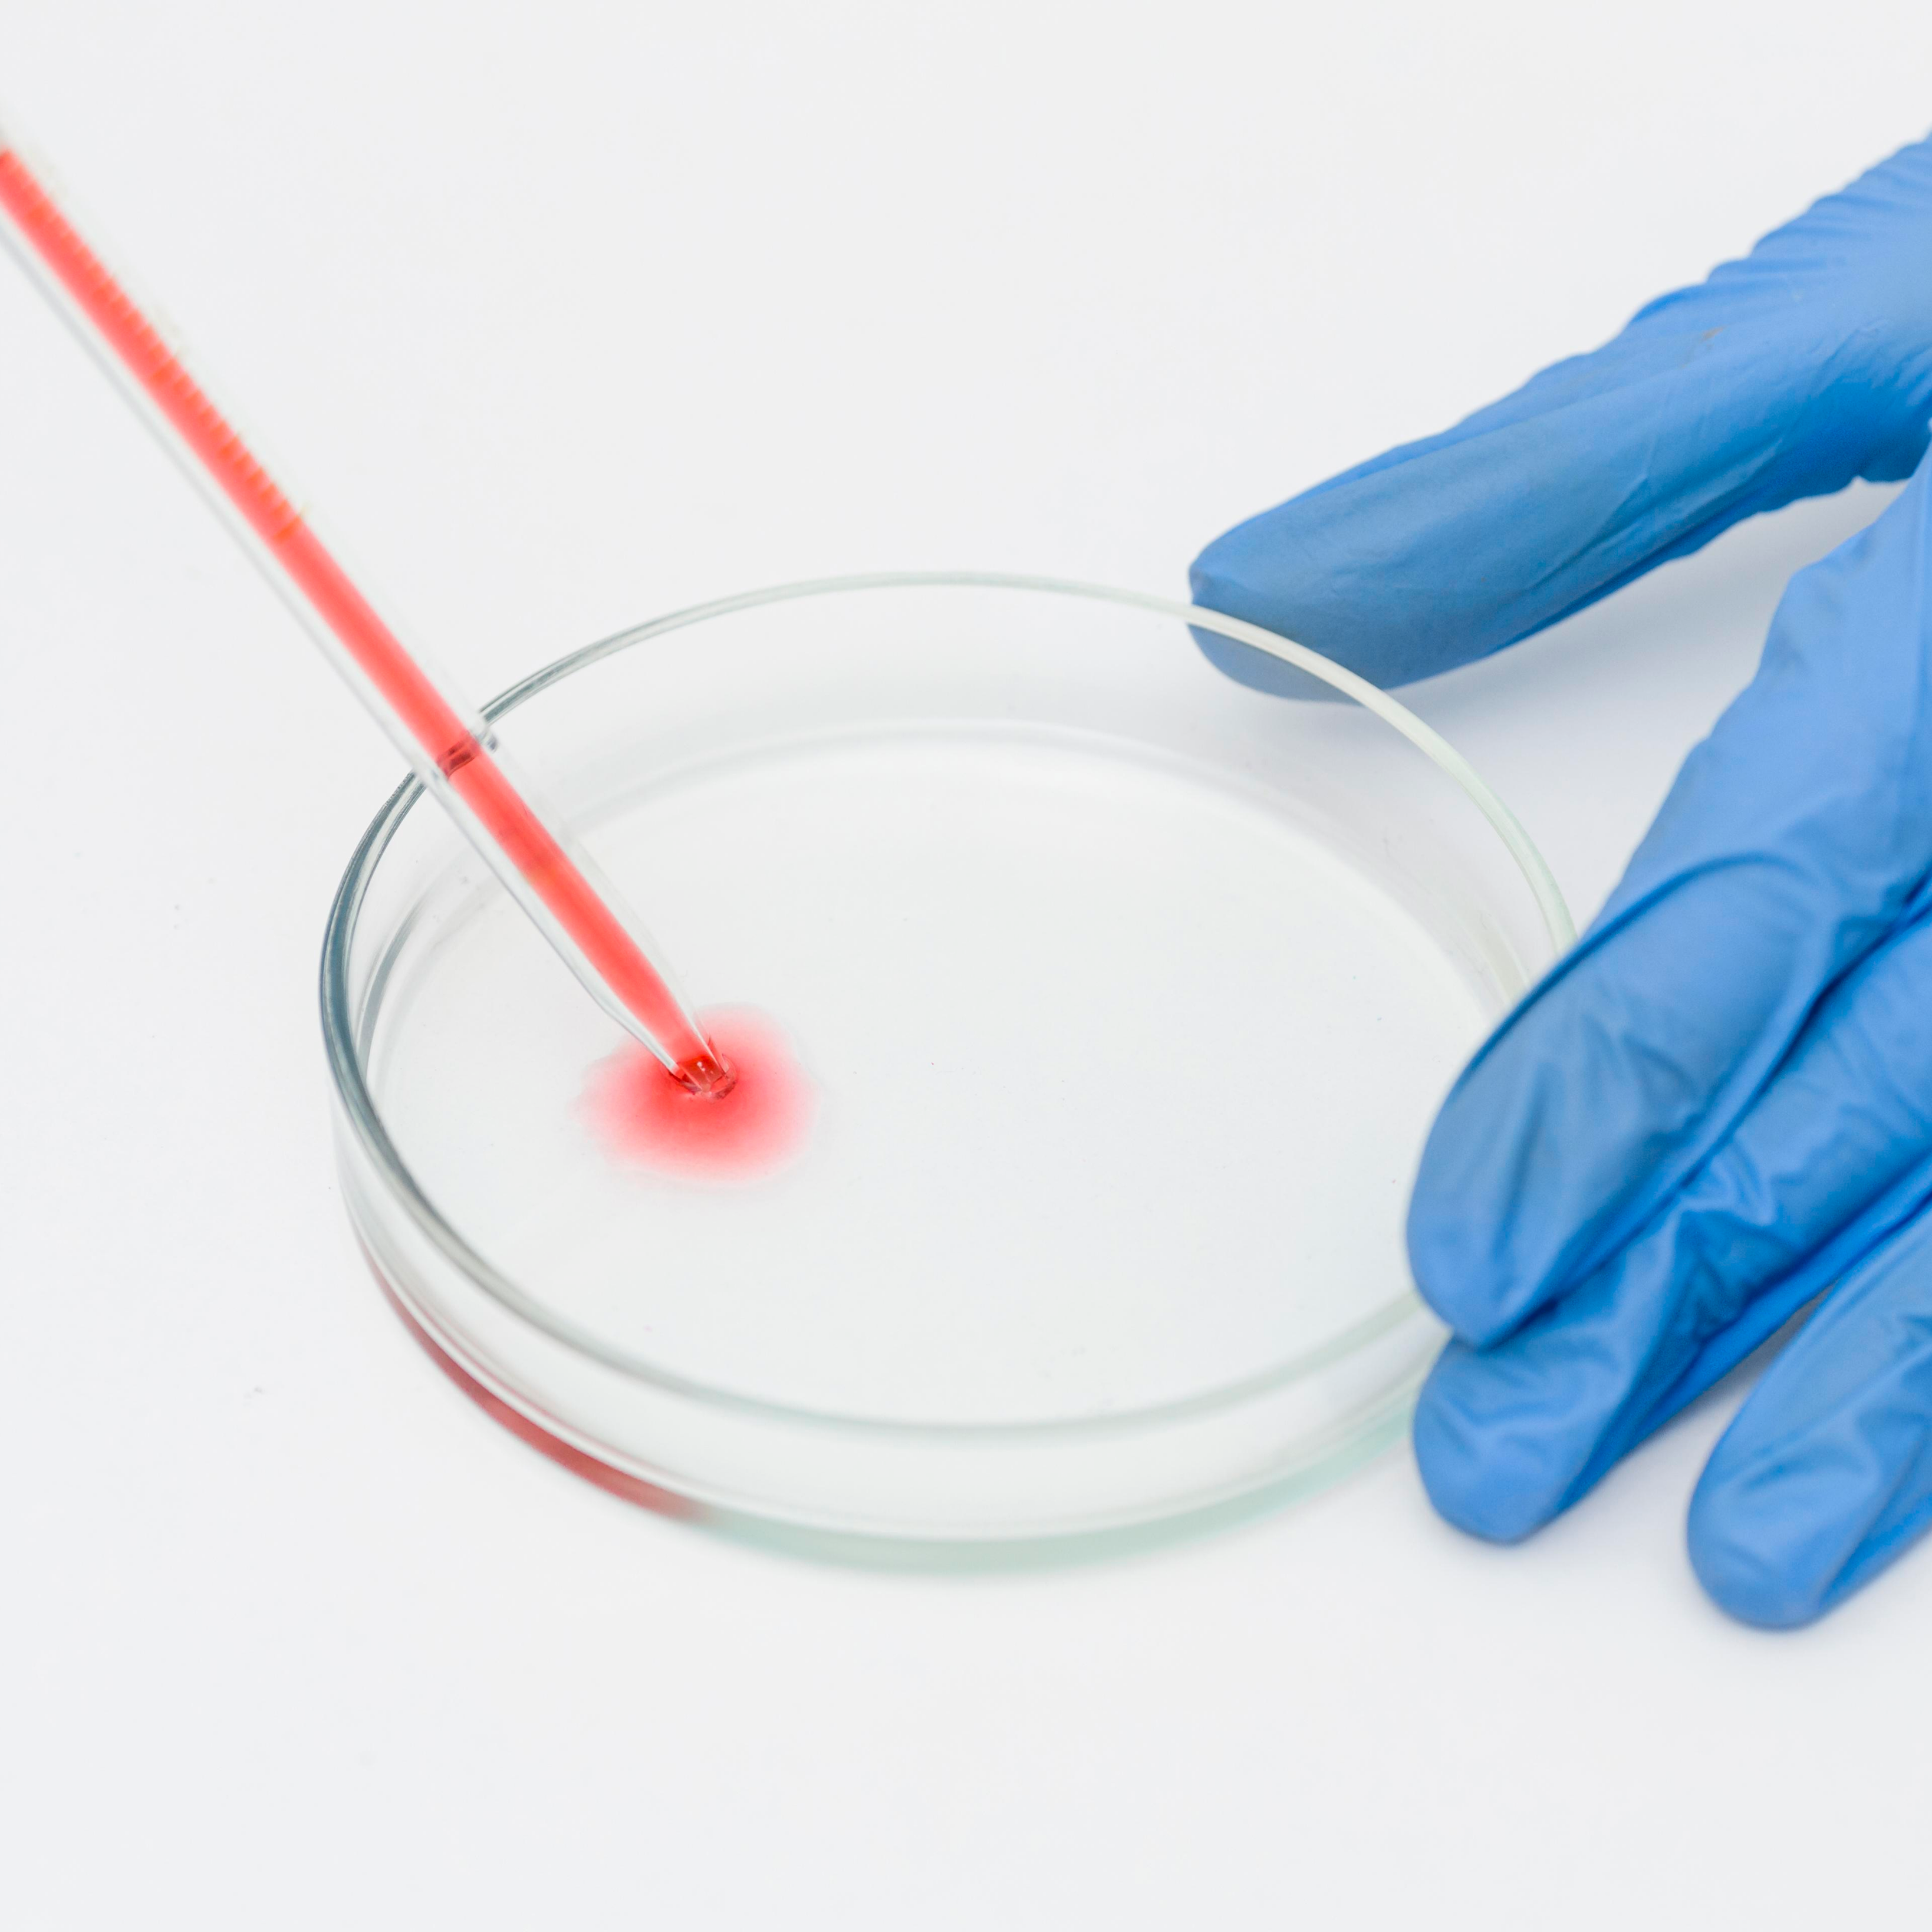

Ветеринарная лаборатория – это специализированное подразделение, где проводятся диагностические исследования для выявления заболеваний у животных. Благодаря современному оборудованию и высококвалифицированным специалистам, лаборатория помогает быстро и точно поставить диагноз, что позволяет назначить эффективное лечение и предотвратить развитие серьезных заболеваний.
– для оценки общего состояния здоровья и выявления воспалений, инфекций.
– помогает выявить нарушения в работе внутренних органов, таких как печень и почки.
– анализы на наличие инфекционных агентов (бактерий, вирусов).
– анализы на наличие антител и оценка иммунного статуса.
– выявление гельминтов и других паразитов.
– для анализа тканей и диагностики опухолей.
500₽
200₽
1 000₽
1 000₽
300₽
1 000₽
2 000₽
2 550₽
200₽
700₽
1 800₽
500₽
100₽
800₽
800₽
950₽
950₽
1 700 - 3 000₽
2 100 - 3 000₽
900 - 14 000₽
800 - 4 000₽
400₽
2 300₽
по договоренности
2 500₽
7 000₽
цены нужно уточнять
1 700₽
2 400₽
1 700₽
950₽ за одну
1 900₽
4 000₽
3 500₽
Наши специалисты проконсультируют бесплатно, круглосуточно / 24 часа
Помогут с заботой о вашем питомце!
Пн-Пт: с 9:00 до 19:00, без перерыва
Преимущества ветеринарной лаборатории нашей клиники:
Современное оборудование и высококачественные реактивы для точных анализов.
Опытные специалисты, работающие с животными всех видов и пород.
Быстрая и точная диагностика, что помогает своевременно назначить лечение.
Полное сопровождение и консультации по результатам исследований.
Запишитесь на консультацию и диагностику
в нашей ветеринарной лаборатории – точная информация для здоровья вашего питомца!

Забор проб – для большинства анализов берутся кровь, моча или биологические жидкости. Для гистологических исследований – ткани или биоптаты.
Обработка и анализ – пробы исследуются с использованием современных методов и оборудования.
Получение результатов – результат можно получить в течение нескольких часов или дней в зависимости от типа исследования.

ТотороМед
До свидания!
BY Ivan Burov
ветеринарная клиника для животных - ветеринарная лабораторная диагностика - ветеринарная ортопедия и травматология - ветеринарная хирургия кота - ветеринарная стоматология и уход - ветеринарная помощь в санкт-петербурге - ветеринарная вакцинация домашних животных - ветеринарная терапия в стационаре - ветеринарная клиника качественных услуг - ветеринарная медицина и кардиология - ветеринарная лаборатория цитологического исследования - ветеринарная консультация врача - ветеринарная хирургия и эндоскопия - ветеринарная диагностика инфекционных заболеваний - ветеринарная экспертиза по вопросам лечения - ветеринарная ортопедическая помощь - ветеринарная вакцинация собак и кошек - ветеринарная помощь с учетом возраста животных - ветеринарная диагностика патологий - ветеринарная лаборатория серологического тестирования - ветеринарная консультация по выбору лечения - ветеринарная стоматология для мелких животных - ветеринарная хирургия с использованием новых технологий - ветеринарная клиника обследования и лечения - ветеринарная помощь при травмах конечностей - ветеринарная лаборатория для анализа крови - ветеринарная клиника для экзотических животных - ветеринарная ортопедия и реабилитация - ветеринарная помощь с учетом индивидуальных особенностей - ветеринарная хирургия для домашних питомцев - лечение животных в санкт-петербурге - диагностика заболеваний животных - ортопедия животных и травматология - вакцинация животных против инфекций - ветеринарная клиника для лечения животных - хирургия животных с применением современных технологий - терапия животных при хронических заболеваниях - лабораторная диагностика животных - кастрация животных в клинике - консультация ветеринара по уходу за животными - реабилитация животных после хирургических вмешательств - эндоскопия животных для точной диагностики - профилактика заболеваний животных - первая помощь для животных - ветеринарная экспертиза здоровья животных - кардиология животных и профилактика болезней сердца - стоматология животных и уход за зубами - контроль веса животных - стерилизация животных в стационаре - цитологическое исследование животных - обследование животных перед операцией - лабораторные анализы животных - реанимация животных в экстренных случаях - уход за пожилыми животными - определение заболеваний животных - лечение травм у животных - онкология животных и методы лечения - анализ крови животных в лаборатории - плановое обследование животных в клинике - подбор рациона для животных - неврология животных и методы терапии - ветеринарная клиника в санкт-петербурге - клиника для животных с полным спектром услуг - современная ветеринарная клиника - клиника диагностики и лечения животных - клиника с лабораторией и хирургическим отделением - клиника для экзотических животных - клиника ортопедической помощи - специализированная ветеринарная клиника - клиника для кастрации и стерилизации - клиника, где делают эндоскопию животным - клиника хирургии и интенсивной терапии - клиника стоматологии для домашних питомцев - клиника кардиологии и УЗИ сердца - клиника травматологии и реабилитации животных - лучшие врачи в ветеринарной клинике - ветеринарная клиника с реанимацией - анализы в ветеринарной клинике - лабораторная диагностика в клинике - хирургия в ветеринарной клинике - клиника с комфортным стационаром для животных - кастрация в клинике без стресса для животных - клиника вакцинации и дегельминтизации - профессиональная помощь в ветеринарной клинике - ветеринарная клиника для мелких и крупных животных - центр диагностики и лечения при клинике - лечение сложных случаев в ветеринарной клинике - клиника лечения онкологических заболеваний у животных - выезд ветеринарной клиники на дом - постоперационный уход в ветеринарной клинике - лучшая ветеринарная клиника по отзывам - услуги ветеринарного центра - услуги хирургии для животных - услуги лабораторных исследований - услуги кастрации и стерилизации - услуги ветеринарной ортопедии - услуги стоматологии для животных - услуги вакцинации собак и кошек - услуги ветеринарной клиники в санкт-петербурге - услуги ветеринара с выездом на дом - услуги по диагностике заболеваний животных - услуги ветеринарной реабилитации - услуги по обследованию животных - услуги по лечению инфекционных болезней - услуги невролога для животных - услуги по реанимации животных - услуги по лечению хронических заболеваний - услуги по кардиологической диагностике - услуги ветеринара для экзотических животных - услуги эндоскопии для животных - услуги ветеринарного стационара - услуги по проведению УЗИ - услуги по анализу крови и мочи животных - услуги по выявлению наследственных заболеваний - услуги по хирургической помощи животным - услуги по лечению травм у животных - услуги по профилактике и вакцинации - услуги ветеринарного консультирования - услуги по исследованию цитологии - услуги по диагностике и профилактике ожирения - услуги по лечению и удалению опухолей - ветеринарная клиника санкт-петербурга - лучшие ветеринарные услуги в санкт-петербурге - хирургия для животных в санкт-петербурге - анализы для животных в санкт-петербурге - ортопедическая помощь животным в санкт-петербурге - стационар для животных в санкт-петербурге - ветеринарный центр санкт-петербурга - вакцинация животных в санкт-петербурге - реабилитация животных в санкт-петербурге - ветеринарные услуги на дому в санкт-петербурге - ветеринарный врач с опытом работы - врач-хирург для животных - врач-ортопед для кошек и собак - врач-анестезиолог в ветеринарной клинике - врач-онколог для животных - врач-кардиолог для диагностики сердца - врач-невролог для животных - врач-реаниматолог для экстренной помощи - врач-дерматолог для лечения кожных заболеваний - врач-гомеопат в ветеринарии - врач-эндоскопист для диагностики - врач-стоматолог для чистки зубов животным - врач-лаборант для исследования анализов - врач по вакцинации животных - врач по кастрации и стерилизации - врач-реабилитолог после травм - врач по лечению хронических заболеваний - врач по лечению инфекционных болезней - врач по травматологии животных - врач общей практики для домашних животных - консультация ветеринарного врача - диагностика у ветеринарного врача - опытный врач для лечения животных - выезд ветеринарного врача на дом - назначение лечения ветеринарным врачом - профилактический осмотр у ветеринарного врача - лечение редких болезней у ветеринарного врача - лучший врач для лечения питомцев - обращение к врачу при первых симптомах - ветеринарный врач по отзывам клиентов - диагностика с лабораторной проверкой - анализ крови с лабораторной точностью - исследование мочи в лабораторной среде - анализ на инфекции с лабораторной проверкой - диагностика паразитов по лабораторной методике - исследование гормонов с лабораторной точностью - тестирование на вирусы с лабораторной проверкой - биохимический анализ по лабораторной технологии - полезные статьи о здоровье животных - статьи по ветеринарной медицине - статьи о профилактике заболеваний - статьи о лечении домашних животных - статьи по хирургии и ортопедии - статьи о стоматологии у животных - научные статьи о ветеринарии - авторские статьи о ветеринарных услугах - статьи о лабораторных исследованиях - контакты ветеринарной клиники - контакты врачей-ветеринаров - контакты для экстренной помощи животным - контакты для записи на приём - контакты службы лабораторных исследований - ветеринарный центр диагностики - центр ветеринарной хирургии - центр лечения домашних животных - многопрофильный ветеринарный центр - центр ортопедии и травматологии - центр экстренной ветеринарной помощи - современный ветеринарный центр - центр терапии и реабилитации животных - центр ветеринарных исследований - центр стоматологии и чипирования - центр лабораторных анализов - центр диагностики инфекционных болезней - специализированный ветеринарный центр - центр профилактики и вакцинации животных - центр наблюдения за послеоперационными пациентами - центр терапии и физиотерапии животных - центр кардиологии и эндоскопии - центр кастрации и стерилизации животных - центр ведения беременности у животных - центр наблюдения за возрастными животными - центр тестирования и анализов - центр ветеринарного обучения и практики - центр экспертизы и оценки состояния здоровья - центр современной ветеринарной хирургии - центр ветеринарного контроля - центр реабилитации после травм - центр комплексного обследования животных - центр помощи бездомным животным - центр по профилактике инфекционных болезней - терапия домашних животных - современная терапия в ветеринарии - методы терапии для животных - терапия хронических заболеваний - эффективная терапия в ветеринарной практике - индивидуальная терапия для питомцев - терапия инфекционных заболеваний - терапия травм и переломов - реабилитационная терапия для животных - терапия после хирургических вмешательств - защита персональных данных в ветеринарии - обработка персональных данных клиентов - защита персональных данных владельцев животных - вакцинация домашних животных - плановая вакцинация собак и кошек - вакцинация против вирусных заболеваний - современные методы вакцинации животных - вакцинация по возрасту и породе - вакцинация для профилактики инфекций - много положительных отзывов о ветеринарной клинике - по отзывам владельцев животных качественное лечение - все отзывы клиентов клиники доступны на сайте - по отзывам клиентов высококвалифицированные врачи - по отзывам пациентов клиника работает круглосуточно - по отзывам ветеринарная клиника удобна для посещения - по отзывам центр оснащен современным оборудованием - по отзывам клиентов лучшие хирурги работают у нас - по отзывам широкий спектр ветеринарных услуг - по отзывам клиентов внимательное отношение к животным - стоматология для домашних животных в клинике - стоматология и уход за зубами питомцев - стоматология собак и кошек с профессиональным осмотром - стоматология и лечение зубов без стресса - стоматология с применением современных технологий - вопросы о здоровье домашних животных - вопросы по диагностике и лечению - вопросы о хирургическом вмешательстве - вопросы по ортопедии у животных - ортопедия для домашних животных - ортопедия и травматология в ветеринарии - материал для исследований в ветеринарии - материал по лечению домашних животных - материал о профилактике заболеваний - материал о хирургическом вмешательстве - хирургия домашних животных в клинике - хирургия мелких домашних животных - хирургия мягких тканей у животных - хирургия и травматология в ветеринарии - хирургия с применением современных технологий - вакансии ветеринарных врачей в клинике - вакансии ассистентов ветеринарного врача - вакансии специалистов по диагностике животных - кастрация домашних животных в клинике - кастрация котов и собак безболезненно - кастрация как метод профилактики заболеваний - кастрация с использованием современных методик - кастрация в ветеринарной клинике безопасно - политика конфиденциальности ветеринарного центра - стоматология для домашних животных в клинике - стоматология и уход за зубами питомцев - стоматология собак и кошек с профессиональным осмотром - стоматология и лечение зубов без стресса - стоматология с применением современных технологий - ветеринарные услуги высокого качества - по отзывам владельцев животных качество лечения на высоте - современные методы диагностики и качество обслуживания - качество работы ветеринарных врачей подтверждено клиентами - высокое качество хирургических операций у животных - новости ветеринарной медицины - новости из мира ветеринарии для владельцев - время работы ветеринарной клиники - время ожидания результатов анализов - направления в области ветеринарной медицины - направления для диагностики заболеваний - направления для ветеринарной хирургии - врач делает осмотр домашних животных - врач делает прививки питомцам - хирург делает операцию по удалению опухоли - официальный сайт ветеринарной клиники - соблюдение конфиденциальности данных владельцев - операция по кастрации кота - лечебные вакцины для животных - определение вида заболевания по анализам - чистые места для осмотра животных - оценка эффективности лечения животных - подсчет дозировки лекарств для животных - современные технологии в ветеринарной медицине - врач ветеринар для кошек и собак - опыт работы с экзотическими животными - опыт в области хирургии животных - роль лабораторных анализов в лечении - глубокие знания ветеринарной медицины - значение ранней диагностики заболеваний - список необходимых вакцин для животных - Ветврач для экзотических животных - индивидуальный подход к каждому животному - рассмотрение заявки на вакцину для питомцев - подробное описание услуг ветеринарной клиники - множество методов диагностики животных - соотношение доз медикаментов для лечения - анализ слюны для диагностики заболеваний - анализ выделений из организма питомца - отсутствие реакции на вакцинацию - исследовательская лаборатория ветклиники - оперативно диагностировано заболевание питомца - проверка качества спермы животного - тестирование на наличие заболеваний у животных - санитарная обработка помещения для животных - сочетание медикаментов для улучшения состояния - разработка инновационных вакцин для животных - наблюдения за состоянием здоровья питомца - снятие болевого синдрома у животных - обнаружение инфекции у животных - проверка здоровья животного - экспертизы качества ветеринарных препаратов - профилактическая дегельминтизация питомцев - прогнозирование эффективности лечения - диагностика заболеваний у кроликов - вакцинация свинок от болезней - лечебные методы при заболеваниях желчи - реконструкция поврежденных тканей - скрининг для диагностики хронических заболеваний -